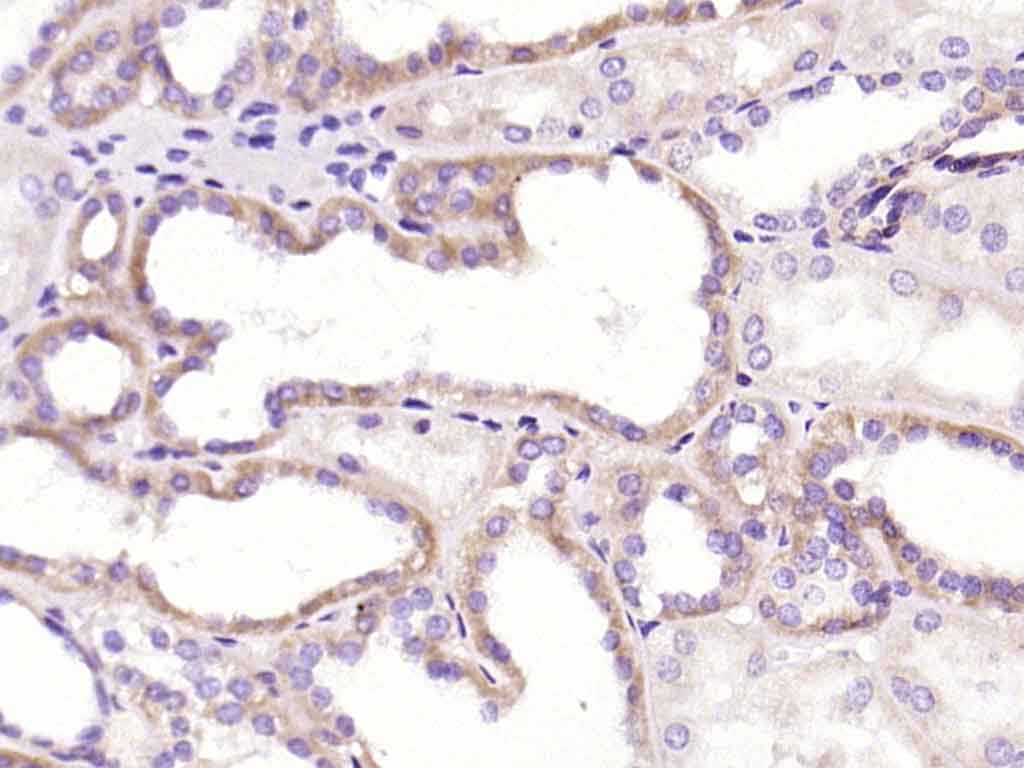
产品细节图片1

相关产品推荐更多 >

SOCS2 Rabbit pAb, HRP conjugated(bs-1896R-HRP)-100ul
¥2980
HPV16 E7 Rabbit pAb, BF750 conjugated(bs-10446R-BF750)-100ul
¥2980
IEX1 Rabbit pAb(bs-6840R)-50ul/100ul/200ul
¥1180
EGF Rabbit pAb, BF680 conjugated(bs-2008R-BF680)-100ul
¥2980
Galectin 3 Rabbit pAb, PerCP-Cy5.5 conjugated(bs-0721R-PerCP-Cy5.5)-100ul
¥2980
万千商家帮你免费找货
0 人在求购买到急需产品
- 详细信息
- 文献和实验
- 技术资料
- 应用范围:
产品信息以Bioss网站为准
- 规格:
50ul/100ul/200ul/200ug
| 规格: | 50ul | 产品价格: | ¥1180.0 |
|---|---|---|---|
| 规格: | 100ul | 产品价格: | ¥1980.0 |
| 规格: | 200ul | 产品价格: | ¥2800.0 |
| 规格: | 200ug | 产品价格: | ¥5600.0 |
| 产品编号 | bsm-0391M |
| 英文名称 | CRP(C11F2) Mouse mAb |
| 中文名称 | C-反应蛋白单克隆抗体 |
| 英文别名 | C-reactive protein; C Reactive Protein; C reactive protein pentraxin related; CRP; MGC88244; PTX 1; PTX1; C-reactive protein(1-205); CRP_HUMAN; Pentraxin 1. |
| 产品应用 | WB=1:500-2000, IHC-P=1:100-500, IHC-F=1:100-500, IF=1:100-500 Not yet tested in other applications. |
| 交叉反应 | Human |
| 抗体来源 | Mouse |
| 免疫原 | Recombinded CRP protein |
| 亚型 | IgG |
| 性状 | Liquid |
| 纯化方法 | affinity purified by Protein A |
| 克隆类型 | Monoclonal |
| 理论分子量 | 25 kDa |
| 浓度 | 1mg/ml |
| 储存液 | 0.01M TBS (pH7.4) with 1% BSA, 0.02% Proclin300 and 50% Glycerol. |
| 研究领域 | Metabolism > Pathways and Processes > Cofactors, Vitamins / minerals > Vitamins / minerals Signal Transduction > Metabolism > Vitamins / Minerals |
| 亚基 | Homopentamer. Pentaxin (or pentraxin) have a discoid arrangement of 5 non-covalently bound subunits. |
| 亚细胞定位 | Secreted. |
| 组织特异性 | Found in plasma. |
| 相似性 | Belongs to the pentaxin family. Contains 1 pentaxin domain. |
| 功能 | Displays several functions associated with host defense: it promotes agglutination, bacterial capsular swelling, phagocytosis and complement fixation through its calcium-dependent binding to phosphorylcholine. Can interact with DNA and histones and may scavenge nuclear material released from damaged circulating cells. |
| 保存条件 | Shipped at 4℃. Store at -20℃ for one year. Avoid repeated freeze/thaw cycles. |
| 注意事项 | This product as supplied is intended for research use only, not for use in human, therapeutic or diagnostic applications. |
| 背景资料 | Pentraxins are plasma proteins characterized by their pentameric discoid assembly and their Ca2+ dependent ligand binding, such as Serum amyloid P component (SAP) and C-reactive Protein (CRP), which are cytokine-inducible acute-phase proteins implicated in innate immunity. CRP binds to ligands containing phosphocholine, SAP binds to amyloid fibrils, DNA, chromatin, fibronectin, C4-binding proteins and glycosaminoglycans. "Long" pentraxins have N-terminal extensions to the common pentraxin domain; one group, the neuronal pentraxins, may be involved in synapse formation and remodeling, and they may also be able to form heteromultimers. |
| 应用 | 推荐稀释比例 |
| {WB} | {1:500-2000} |
| {IHC-P} | {1:100-500} |
| {IHC-F} | {1:100-500} |
| {IF} | {1:100-500} |

Lane 1: U2os (Human) Cell Lysate at 30 ug
Lane 2: Siha (Human) Cell Lysate at 30 ug
Primary:
Anti- CRP (bsm-0391M) at 1/1000 dilution
Anti- beta-Actin (bs-0061R) at 1/2000 dilution
Secondary: IRDye800CW Goat Anti-Mouse IgG at 1/20000 dilution
IRDye800CW Goat Anti-Rabbit IgG at 1/20000 dilution
Predicted band size: 25 kD
Observed band size: 26 kD

风险提示:丁香通仅作为第三方平台,为商家信息发布提供平台空间。用户咨询产品时请注意保护个人信息及财产安全,合理判断,谨慎选购商品,商家和用户对交易行为负责。对于医疗器械类产品,请先查证核实企业经营资质和医疗器械产品注册证情况。
文献和实验[IF={{ 15.881 }}] {Maoze Guo. et al. Shark Tooth-Inspired Microneedle Dressing for Intelligent Wound Management. Acs Nano. 2021;15(9):15316–15327} {Other} {material}
[IF={{ 11.092 }}] {Baoyang Lin. et al. Patterned Duplex Fibric based on Genetically Modified Spidroin for Smart Wound Management. ADV HEALTHC MATER. 2022 Nov;:2202213} {Other} {Mouse}
[IF={{ 0.5 }}] {Zhou, Mingxue, et al. "The effect of hydroxy safflower yellow A on inflammatory reaction in myocardium of the rats after acute myocardial infarction." African Journal of Pharmacy and Pharmacology 7.12 (2013): 643-649.} {IHC} {="Rat"}
T-Cell Activation Using mAb to CD3
splenic T-cells and human peripheral T cells stimulated via CD3. Critical parameters include cell density, antibody titer and activation kinetics. Materials 1X sterile PBS Anti-mouse CD3e, Clone 145-2C11 (Functional Grade, Cat. No. 16
ELISPOT (Enzyme-linked ImmunoSPOT)
Mouse Cytokine ELISPOT Set Catalog No. Capture mAb Detection mAb IFN-γ 88-7384 AN-18 R4-6A2 IL-1α 88-7813 ALF-161 Rabbit
Intracellular Cytokine Staining Protocol
. More antibodies are in development; if you do not see an antibody of your choice, please send us an e-mail so we may provide you timely product updates.Table 1: Mouse Cytokine Intracellular Staining Quick Guide Mouse CytokineCell SourceActivationIncubation
技术资料暂无技术资料 索取技术资料






